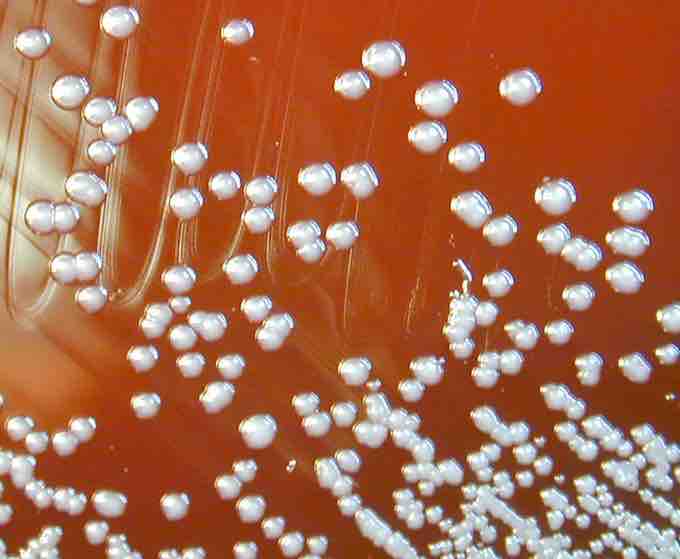

Betaproteobacteria is a class of Proteobacteria that are all Gram-negative.
The Betaproteobacteria consist of several groups of aerobic or facultative bacteria that are often highly versatile in their degradation capacities, but also contain chemolithotrophic genera (e.g., the ammonia-oxidising genus Nitrosomonas) and some phototrophs (members of the genera Rhodocyclus and Rubrivivax).
Nitrosomonas is a genus comprising rod shaped chemoautotrophic bacteria. This rare bacteria oxidizes ammonia into nitrite as a metabolic process. Nitrosomonas are useful in treatment of industrial and sewage waste and in the process of bioremediation. They play an important role in the nitrogen cycle by increasing the availability of nitrogen to plants while limiting carbon dioxide fixation.
Betaproteobacteria play a role in nitrogen fixation in various types of plants, oxidizing ammonium to produce nitrite- an important chemical for plant function. Many of them are found in environmental samples, such as waste water or soil. Pathogenic species within this class are the Neisseriaceae (gonorrhea and meningitis) and species of the genus Burkholderia .
Betaproteobacteria
Burkholderia pseudomallei colonies on a Blood agar plate.
Burkholderia is a genus of proteobacteria probably best known for its pathogenic members: Burkholderia mallei, responsible for glanders, a disease that occurs mostly in horses and related animals; Burkholderia pseudomallei, causative agent of melioidosis; and Burkholderia cepacia, an important pathogen of pulmonary infections in people with cystic fibrosis (CF). The Burkholderia (previously part of Pseudomonas) genus name refers to a group of virtually ubiquitous gram-negative, motile, obligately aerobic rod-shaped bacteria including both animal/human (see above) and plant pathogens as well as some environmentally important species.
The currently accepted taxonomy is based on the List of Prokaryotic names with Standing in Nomenclature (LPSN) and National Center for Biotechnology Information (NCBI) and the phylogeny is based on 16S rRNA-based LTP release 106 by 'The All-Species Living Tree' Project.